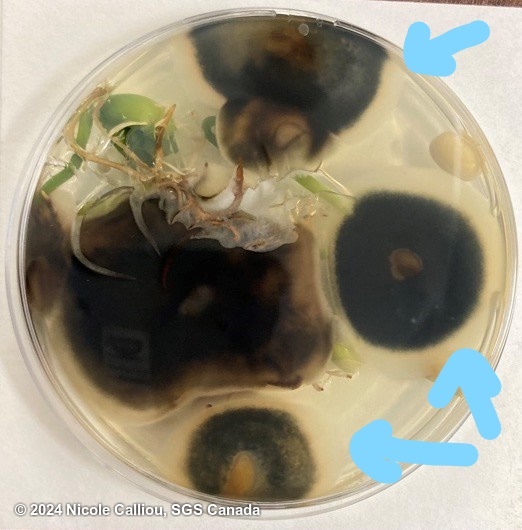

Colletotrichum lindemuthianum
Overview
|
Scientific name
|
Colletotrichum lindemuthianum |
|
Genus
|
Colletotrichum |
|
EPPO code
|
COLLLD |
|
Common name
|
Anthracnose |
|
Synonyms
|
|
Description
From ISTA method 7-006:
After 7 days of growth in an appropriate chamber, remove seed coats and examine cotyledons for black depressed ares with well delimited outlines. Check easch spot for presence of acervuli with or without dark brown setae using x25 magnification.
The septate setae measure approx. 6 x 100 um. The pale orange acervuli contain cylindric, hyaline conidia with rounded ends containing one or two guttulaes. Conidia measure 2.5-5.5 x 11-20 um (Mordue, 1971; Kulshreshtha, Mathur & Neergaard, 1976). Colonies on PDA are often described as 'dirty white' or 'light grey' in coloration, although they tend to darken with age.
From ISTA's Common Laboratory Seed Health Testing Methods for Detecting Fungi:
Acervuli mostly in groups, coalescing and covering the seed, rarely single. Setae few, longer than the conidial mass. Conidial mass orange to bright orange. Mycelium scanty, white.
Conidia hyaline, oblong to dumbel shaped, 1-celled, straight, ends rounded, 9-15 x 3-4μm.